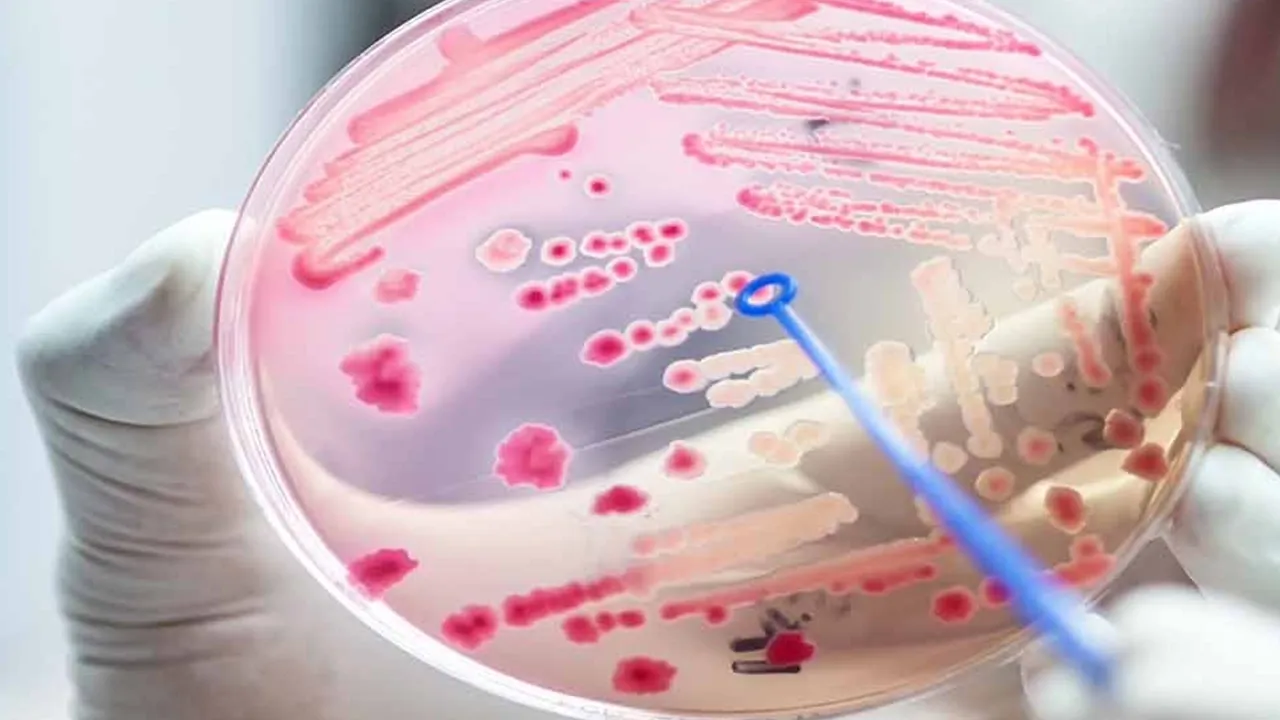

Her yıl 13 Eylül günü, Dünya Sepsis Günü olarak kabul ediliyor. Halk arasında “kan zehirlenmesi” olarak da bilinen sepsis; vücudun enfeksiyona karşı verdiği kontrolsüz savunma tepkisi sonucunda kendi doku ve organlarına hasar vermesidir. Sepsis, tanınmadığı veya acil tedavi edilmediği durumlarda organ yetmezliğine ve ölüme neden olabilir.
TTD Merkez Yönetim Kurulu Üyesi Prof. Dr. Gaye Ulubay, sepsisin dünya genelinde sağlığı
tehdit eden bir durum haline geldiğini belirterek, “Özellikle gelişmekte olan ülkelerde daha
sık görülmektedir. Birçok ülkede, sepsise bağlı ölüm oranları diğer hastalıklara bağlı ölüm
oranlarından daha yüksektir. Dünyada yılda yaklaşık 50 milyon bireyi etkileyen ve 11 milyona
yakın ölüme neden olan sepsis, her 3 saniyede bir can kaybına neden olur.” dedi.
Sepsis Nedir?
Sepsis, vücuttaki bir enfeksiyonun neden olduğu aşırı yanıtın sonucunda gelişen bir durumdur. Vücut, enfeksiyonu kontrol etmek için bağışıklık sistemi aracılığıyla savaşırken, sepsis sırasında vücut, yanlışlıkla kendi hücrelerine zarar verir. Bu durum organlarda hasara ve işlev bozukluğuna yol açabilir.
Sepsis Belirtileri Nelerdir?
Sepsis belirtileri, enfeksiyonun tipine ve vücudun tepkisine bağlı olarak değişebilir. Ancak genellikle ateş, titreme, hızlı nabız, hızlı solunum, zihinsel karışıklık, düşük idrar çıkışı ve ciltte renk değişiklikleri gibi belirtiler görülebilir.
Sepsis Nasıl Tedavi Edilir?
Sepsis acil bir tıbbi durumdur ve hemen tedavi edilmelidir. Tedavi genellikle hastanede yapılır ve antibiyotikler, sıvı tedavisi, oksijen tedavisi ve diğer destekleyici önlemleri içerebilir. Erken teşhis ve tedavi, sepsis tedavisinde hayati bir öneme sahiptir.

Sepsis Risk Faktörleri ve Önleme
Sepsis her yaşta görülebilir, ancak bazı risk faktörleri hastalık riskini artırabilir. Bu faktörler arasında yaşlılık, zayıf bağışıklık sistemi, kronik hastalıklar, cerrahi müdahaleler ve enfeksiyonlar bulunmaktadır. Sepsis riskini azaltmak için hijyen kurallarına dikkat etmek, aşılarını güncellemek ve enfeksiyonlardan kaçınmak önemlidir.